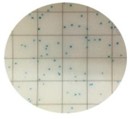

The Scigiene Rapid Listeria kit incorporates a Letheen swab to neutralize residual sanitizers to improve recovery. The DiluSwab included also facilitates direct pipetting of 1ml of the broth to the MicroFast Listeria plate, to allow for enumerative detection of Listeria spp. including L. monocytogenes from food contact/preparation areas or manufacturing environments where regular disinfecting/sanitizing is performed. Results are easily visualized by counting Blue/green colonies of the MicroFast plate after 18-24 hours incubation at 36°C.
Ideal For: Detecting Listeria spp.
including L. monocytogenes from food contact surfaces,
equipment or environmental. Routine Sampling for Pathogens is a
fundamental part of Good Manufacturing Practice (GMP) and essential for
adhering to a HACCP (Hazard Analysis Critical Control Points) plan. This product
can be used to compliment (or in conjunction with) the ISO11290-1
testing/detection methodology.
Limitations:
1. Scigiene Rapid Listeria kit is intended as a screening test. All
positive results should be confirmed by standard or molecular bacteriological
methods.
2. Has not been validated for uncleaned food surfaces. The
use of Scigiene Rapid Listeria kit for
these purposes may result in false positives or spurious/unreadable results. If
you wish to test products for Listeria please call your Scigiene rep for
assistance.
3. The absence of a colonies does not necessarily imply the absence of target bacteria. Reasons for this may include:
4. The Incubation temperature can have an effect on false
positive rate. A temperature of 36°C is recommended and will result in fewer
false positive results. This is particularly important when sampling areas that
are difficult to maintain e.g. Drains, intricate equipment.
Shelf Life: Up to 12 months -
Components should not be used after the expiry date printed on them or the
carton label.
Storage: Store at 2-8°C when not in use. The
pre-moistened swabs should be stored at 4-25°C.
Sterilization Method: Terminally Sterilized (detection media autoclaved, swab gamma irradiated)
Method of Use:

Read Results: